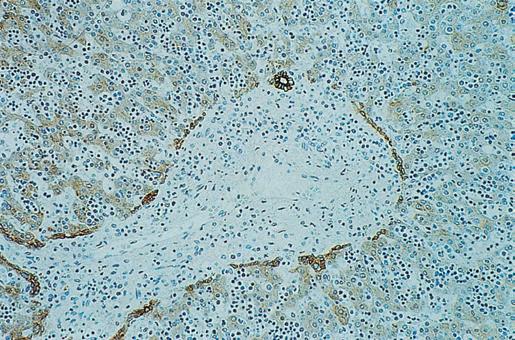

MacSween’s Pathology of the Liver
SEVENTH EDITION
Alastair D. Burt, BSc, MBChB, MD, FRCPath, FRCPA, FRCP, FRSB, FAHMS
Executive Dean Faculty of Health and Medical Sciences University of Adelaide Adelaide, Australia
Linda D. Ferrell, MD Emerita Professor Anatomic Pathology University of California San Francisco San Francisco, California
Stefan G. Hübscher, MBChB, FRCPath
Leith Professor and Professor of Hepatic Pathology Institute of Immunology and Immunotherapy University of Birmingham Birmingham, United Kingdom
1600 John F. Kennedy Blvd.
Ste 1800 Philadelphia, PA 19103-2899
MacSween’s Pathology of the Liver, ed. 7 ISBN: 978-0-7020-6697-9
Copyright © 2018 by Elsevier, Ltd. All rights reserved.
No part of this publication may be reproduced or transmitted in any form or by any means, electronic or mechanical, including photocopying, recording, or any information storage and retrieval system, without permission in writing from the publisher. Details on how to seek permission, further information about the Publisher’s permissions policies and our arrangements with organizations such as the Copyright Clearance Center and the Copyright Licensing Agency, can be found at our website: www.elsevier.com/permissions
This book and the individual contributions contained in it are protected under copyright by the Publisher (other than as may be noted herein).
Notices
Knowledge and best practice in this field are constantly changing. As new research and experience broaden our understanding, changes in research methods, professional practices, or medical treatment may become necessary.
Practitioners and researchers must always rely on their own experience and knowledge in evaluating and using any information, methods, compounds, or experiments described herein. In using such information or methods they should be mindful of their own safety and the safety of others, including parties for whom they have a professional responsibility.
With respect to any drug or pharmaceutical products identified, readers are advised to check the most current information provided (i) on procedures featured or (ii) by the manufacturer of each product to be administered, to verify the recommended dose or formula, the method and duration of administration, and contraindications. It is the responsibility of practitioners, relying on their own experience and knowledge of their patients, to make diagnoses, to determine dosages and the best treatment for each individual patient, and to take all appropriate safety precautions.
To the fullest extent of the law, neither the Publisher nor the authors, contributors, or editors, assume any liability for any injury and/or damage to persons or property as a matter of products liability, negligence or otherwise, or from any use or operation of any methods, products, instructions, or ideas contained in the material herein.
Previous editions copyrighted 2012, 2007, 2002, 1994, 1997, and 1979 by Elsevier, Ltd.
Library of Congress Cataloging-in-Publication Data
Names: Burt, Alastair D., editor. | Ferrell, Linda D., editor. | Hübscher, Stefan G., editor.
Title: MacSween’s pathology of the liver / [edited by] Alastair Burt, Linda D. Ferrell, Stefan Hübscher
Other titles: Pathology of the liver
Description: Seventh edition. | Philadelphia, PA : Elsevier, [2018] | Includes bibliographical references and index.
Identifiers: LCCN 2016044715 | ISBN 9780702066979 (hardcover)
Subjects: | MESH: Liver Diseases—pathology | Liver Diseases—physiopathology
Classification: LCC RC847 | NLM WI 700 | DDC 616.3/6207–dc23 LC record available at https://lccn.loc.gov/2016044715
Executive Content Strategist: Michael Houston
Senior Content Development Specialist: Jennifer Ehlers
Publishing Services Manager: Patricia Tannian
Project Manager: Stephanie Turza
Design Direction: Ryan Cook
Preface
The three current editors of MacSween’s Pathology of the Liver wish to take the opportunity to pay tribute to the visionary leadership and inspiration of the main initiator for the very first edition, Roddy MacSween, who sadly died on 11 December 2015 at the age of 80 after a long illness. His legacy to pathology and more broadly in medicine shall never be forgotten. Obituaries to Roddy have been published widely—by The Herald Scotland, The Lancet, the Royal Philosophical Society of Glasgow, and many others—and our brief words here barely do justice to his immense influence.
Roderick (Roddy) Norman McIver MacSween was born in 1935 on the Isle of Lewis in Scotland. He excelled in secondary education in Skye and Inverness and went on to study at the University of Glasgow, graduating BSc with Honours in Physiology in 1956 and then MBChB three years later.
His postgraduate house officer year was spent in Glasgow’s Royal and Western Infirmaries where he subsequently went on to gain experience in clinical medicine and infectious diseases. He joined the University Department of Pathology at the Western Infirmary shortly after that. The then-Professor of Pathology, Dan Cappell, had a vision of sub-specialisation in histopathology, a model that has been widely embraced around the globe. Early in his pathology training, Roddy was stimulated by his postmortem findings of patients with iron overload and chose to develop an interest in liver disease, a field in which he went on to build an international reputation.
After gaining his MRCPath in 1967, he was seconded by Cappell to University of Colorado Medical Center, where he worked closely with clinical gastroenterologists who were developing the new discipline of hepatology. He returned to Glasgow in 1970 as a Wellcome Senior Research Fellow working with Professor John Anderson on clinico-pathological and immunological studies in liver disease. He made outstanding contributions to our understanding of autoimmune liver disorders, in particular the disease that was then known as primary biliary cirrhosis. He was awarded an MD with honours for this work. He progressed through the ranks of Senior Lecturer, Reader, and Titular Professor, and in 1994 succeeded Anderson as the sixth Chair of Pathology at the Western Infirmary and Head of Department, positions he held until retirement in 1999.
He became an outstanding interpreter of liver biopsies with a national and international reputation and a substantial worldwide referral practice. In 1978, he was invited to join a group of distinguished international hepatopathologists that had become established under the aegis of the European Association for the Study of the Liver in 1968. This group was known as the Gnomes, as their first meeting had been held in Zurich (a term coined by the late Dame
Shelia Sherlock). Roddy was a very active member of this group, which over the years has made significant contributions to our understanding of the classification and histological assessment of liver disease. He was the original sponsor for two of the current editors (ADB and SGH) for election to the group, and we are both indebted to him for the opportunities that this brought.
He served as President of the Royal College of Pathologists from 1996 to 1999. He was highly regarded by his peers in other medical disciplines, and he served as Chairman of the Academy of Medical Royal Colleges from 1998 to 2000. He retired in 1999 and was knighted in 2000 for services to Medicine and Pathology. He was awarded a DSc from his alma mater in 2007, one of several honorary titles bestowed upon him.
Roddy was a wonderful mentor and supervisor to many whose careers have been heavily influenced by him. All three of us feel very fortunate to count ourselves amongst a large number of individuals whom he encouraged and supported in their pursuit of an understanding of liver disease. His enthusiastic professional support was not by any means restricted to those wanting to learn about the liver. Generations of pathologists who had come through the Western either as local trainees or as visitors from elsewhere in the UK or overseas fell under his tutelage.
Readers of this book will of course most likely know him best for establishing it as the key international textbook in its field. In 1979, Roddy published the first edition of Pathology of the Liver with Peter Anthony and Peter Scheuer as co-editors. As a young medical student, one of us (ADB) had the privilege of proofreading the entire edition. It rapidly became the standard text for both pathologists and hepatologists worldwide. Its comprehensive nature was reflected in a review that stated, “If it’s not in MacSween it’s not in the liver”. The fifth edition in 2006 was retitled MacSween’s Pathology of the Liver in recognition of the leadership he had shown in developing it as an enduring concept.
The current edition sees a number of important changes. There is coverage of new technologies, such as next generation sequencing, which are beginning to contribute to the phenotyping and genotyping of hepatic disorders, in particular, hepatic neoplasms. The subjects of inherited and developmental liver disease have been combined into a single chapter, which includes an algorithmic approach to the pathological assessment of paediatric liver disease. New scoring systems and approaches to the assessment of the fatty liver diseases are outlined. Additional outstanding figures have been included in the chapter on non-hepatotropic infections with up-to-date coverage on emerging infections. The chapter on drugs and the liver has been
extensively updated, as has the chapter on vascular disorders. Tumours and tumour-like lesions are more comprehensively covered than ever before and recent developments in clinical management and pathological assessment in the field of hepatic transplantation are reflected in an updated section on this importance topic. As always we have attempted to ensure the use of contemporary terms throughout. In recent years the term “primary biliary cholangitis” has replaced the term “primary biliary cirrhosis”. This is a change that we fully support and have therefore adopted the new terminology in this edition.
For each of us, the editing of this book has been a labour of love; we are honoured to be able to continue the fine tradition that Roddy started almost 40 years ago. We are grateful for the ongoing support and encouragement of our respective partners, Alison, Rick, and Dawn, during the preparation of the book. Thanks also to all of the contributors and the team at Elsevier for keeping us on track.
Alastair D. Burt
Linda D. Ferrell
Stefan G. Hübscher
List of Contributors
N. Volkan Adsay, MD
Professor and Vice-Chair Director of Anatomic Pathology
Emory University Atlanta, Georgia
Venancio A. F. Alves, MD, PhD
Professor Department of Pathology
University of Sao Paulo School of Medicine; Director
CICAP-Anatomic Pathology
Hospital Alemao Oswaldo Cruz Sao Paulo, Brazil
Quentin M. Anstee, MB, BS, PhD, FRCP
Professor of Experimental Hepatology
Honorary Consultant Hepatologist Institute of Cellular Medicine
Newcastle University Newcastle upon Tyne, United Kingdom
Pierre Bedossa, MD, PhD
Professor Department of Pathology Hôpital Beaujon Clichy, France; University Paris Paris, France
Chris Bellamy, MBBS, PhD, FRCPath
Department of Pathology
University of Edinburgh Edinburgh, United Kingdom
Paulette Bioulac-Sage, MD
Professor Emeritus
University Bordeaux Bordeaux, France
Henry Charles Bodenheimer Jr., MD
Professor of Medicine
Hofstra Northwell School of Medicine
Sandra Atlas Bass Center for Liver Disease Northwell Health Manhasset, New York
Alastair D. Burt, MBChB, MD, FRCPath, FRCPA, FRCP, FRSB, FAHMS
Executive Dean Faculty of Health and Medical Sciences University of Adelaide Adelaide, Australia
Andrew D. Clouston, MBBS, PhD, FRCPA
Managing Partner Envoi Specialist Pathologists; Professor
Molecular and Cellular Pathology University of Queensland Brisbane, Queensland, Australia
James M. Crawford, MD, PhD
Department of Pathology and Laboratory Medicine
Hofstra Northwell School of Medicine Hempstead, New York
Linda D. Ferrell, MD
Emerita Professor
Anatomic Pathology
University of California San Francisco San Francisco, California
Maria Guido, MD
Professor
Department of Medicine
Anatomic Pathology Unit
University of Padova Padova, Italy
Gillian L. Hale, MD, MPH
Staff Pathologist
Infectious Diseases Pathology Branch Centers for Disease Control and Prevention Atlanta, Georgia
Stefan G. Hübscher, MBChB, FRCPath
Leith Professor and Professor of Hepatic Pathology Institute of Immunology and Immunotherapy University of Birmingham Birmingham, United Kingdom
Prodromos Hytiroglou, MD
Professor Department of Pathology
Aristotle University Medical School Thessaloniki, Greece
Sanjay Kakar, MD
Professor
Department of Anatomic Pathology University of California, San Francisco San Francisco, California
David E. Kleiner, MD, PhD
Chief, Post-Mortem Section Laboratory of Pathology
National Cancer Institute Bethesda, Maryland
Michael P. Manns, MD
Professor and Chairman
Department of Gastroenterology, Hepatology, and Endocrinology
Medical School of Hannover Hannover, Germany; Helmholtz Center for Infection Research (HZI) Braunschweig, Germany
Yasuni Nakanuma, MD, PhD
Professor Emeritus
Department of Human Pathology Kanazawa University Graduate School of Medicine Kanazawa, Japan
Valerie Paradis, MD, PhD
Professor Department of Pathology Beaujon Hospital Clichy, France
Antonello Pietrangelo, MD, PhD
Professor of Medicine
Medical and Surgical Sciences University Hospital of Modena Modena, Italy
Alberto Quaglia, MD, PhD, FRCPath
Consultant Histopathologist/Honorary Reader
Institute of Liver Studies
King’s College Hospital/King’s College London London, United Kingdom
Brian C. Quigley, MD
Assistant Professor
Department of Pathology and Laboratory Medicine
Emory University School of Medicine Atlanta, Georgia
Eve A. Roberts, MD, PhD, FRCPC
Adjunct Professor
Paediatrics, Medicine, and Pharmacology & Toxicology
University of Toronto
Adjunct Scientist
Genetics and Genome Biology Program
Hospital for Sick Children Research Institute Toronto, Ontario, Canada
Jessica Zucman-Rossi, MD, PhD
Professor of Medicine
Oncology
University Paris Descartes Hopital Européen Georges Pompidou Paris, France
Luigi M. Terracciano, MD
Professor Department of Pathology
University Hospital Basel Basel, Switzerland
Neil D. Theise, MD
Professor Department of Pathology
New York University School of Medicine New York, New York,
Dina G. Tiniakos, MD, PhD, FRCPath
Senior Lecturer
Institute of Cellular Medicine
Faculty of Medical Sciences
Newcastle University Newcastle upon Tyne, United Kingdom; Associate Professor/Consultant Pathologist Department of Pathology
Aretaieio Hospital Medical School
National and Kapodistrian University of Athens Athens, Greece
Michael Torbenson, MD
Professor of Laboratory Medicine and Pathology
Mayo Clinic Rochester, Minnesota
Kay Washington, MD, PhD
Professor of Pathology
Vanderbilt University Medical Center Nashville, Tennessee
Aileen Wee, MB, BS, FRCPath, FRCPA
Professor of Pathology and Senior Consultant
Department of Pathology
Yong Loo Lin School of Medicine, National University of Singapore; National University Hospital Singapore
Matthew M. Yeh, MD, PhD
Associate Professor
Director of Gastrointestinal and Hepatic Pathology
Pathology
University of Washington School of Medicine Seattle, Washington
Sherif R. Zaki, MD, PhD
Chief, Infectious Diseases Pathology Branch
Centers for Disease Control and Prevention Atlanta, Georgia
Yoh Zen, MD, PhD, FRCPath
Professor of Pathology
Department of Diagnostic Pathology
Kobe University Graduate School of Medicine Kobe, Japan
Structure, Function, and Responses to Injury
James M. Crawford, Paulette Bioulac-Sage, and Prodromos Hytiroglou
Keywords
Inflammation
Regeneration
Fibrosis
Vascular Remodeling
Regression
Cirrhosis
The practice of hepatopathology requires a clear understanding of liver anatomy and physiology, as a prelude to understanding the expression of pathological processes in the liver. As an anatomical entity, the liver is deceptively simple. It is large, representing about 2% of the total body mass of an adult human and occupying most of the right upper quadrant of the abdomen. It has a roughly triangular profile, with incomplete clefts helping to define the different ‘lobes’ of the liver. It has only one point of vascular inflow, the porta hepatis. Blood exits through several venous orifices into the inferior vena cava, which traverses a deep groove in the dorsum of the liver. There are no ‘moving parts’ of the liver, with the exception of daily secretion of several litres of bile into the common hepatic duct, which exits from the porta hepatis.
Belying its macroscopic simplicity, the liver is home to biosynthetic and biodegradative metabolic pathways of unequaled complexity, generating enough metabolic heat to be a prime source of core homeostatic temperature maintenance. This chapter considers the embryology, macroanatomy and microanatomy of the liver and its basic response to injury, concluding with the appearance of ‘normal’ liver in biopsy and autopsy specimens.
Development of the liver
General features
In human embryos the liver first appears at the end of the third week of development. The liver bud, or hepatic diverticulum, arises as a hollow midline outgrowth of endodermal tissue from the ventral wall of the future duodenum. The connective tissue framework of the liver into which the endodermal bud grows is of mesenchymal origin and develops from two sources: (1) the septum transversum, a transverse sheet of mesenchymal cells that incompletely separates the pericardial and peritoneal cavities and is the primordium for both the diaphragm and the liver, and (2) cells derived from the mesenchymal lining of the associated coelomic cavity, which actively invade the septum transversum. The confluence of endodermal cells from the hepatic diverticulum growing into the mesenchymal primordium creates the solid organ destined to become the liver (Fig. 1.1).


During the fourth week, buds of epithelial cells within the mesenchymal stroma extend radially out from the hepatic diverticulum. Between the epithelial cords, a plexus of vascular hepatic sinusoids develops. As the epithelial buds grow into the septum transversum, they break up into thick, anastomosing epithelial sheets that meet and enmesh vessels of the hepatic sinusoidal plexus, forming the primitive hepatic sinusoids (Fig. 1.2 A). The intimate relation between hepatocytes and sinusoidal capillaries, so characteristic of the adult organ, is therefore already anticipated in the 4-week-old embryo. The hepatic diverticulum remains as a tether between the developing liver primordium and the duodenum, ultimately becoming the extrahepatic biliary tree.
Once established, the liver grows rapidly during the fetal period, to become the largest single visceral organ (by mass) for the remainder of gestation. It bulges into the peritoneal cavity on each side of the midline, as right and left lobes, which are initially symmetrical. It also grows ventrally and caudally into the mesenchyme of the anterior abdominal wall, extending down to the umbilical ring. Associated with these changes, the stomach and duodenum, which were initially in broad contact with the septum transversum, draw away from it, thus producing a midsagittal sheet of mesoderm, the ventral mesogastrium or future lesser omentum. As the duodenum withdraws from the septum transversum, the stalk of the original hepatic diverticulum is also drawn out to form, within the lesser omentum, the epithelial elements of the extrahepatic bile ducts. Simultaneously, the cephalad aspect of the liver becomes partly freed from its originally broad contact with the septum transversum by extensions of the peritoneal cavity and its visceral and parietal mesothelial surfaces so that, in the adult, direct contact of the liver with the diaphragm persists only as the ‘bare area’ of the liver. This is bounded by the attachments of peritoneal reflections, which form the coronary and falciform ligaments.
Vascular arrangements
By the fifth week of development (in embryos of 5 mm), the liver parenchyma consists of anastomosing sheets of liver cells, each sheet being several cells in thickness. Coursing between the liver cells is the vascular ‘sinusoidal plexus’. Initially, the afferent hepatic blood supply is through the symmetrically arranged vitelline veins returning from the abdominal region of the embryo. Blood is also received from the laterally placed right and left umbilical veins, which run in the body wall and carry oxygenated blood from the placenta directly to the paired horns of the sinus venosus of the cardiac primordium. Both the vitelline and the umbilical sources of blood enter into the hepatic sinusoidal plexus through a developing branching vascular network. Blood draining from the sinusoidal plexus passes through symmetrical right and left hepatocardiac channels, to enter the sinus venosus through this same network1 (Fig. 1.2 B). This network, along with the mesenchyme through which it passes, constitutes the early portal tract system within the liver parenchyma.
1.1 Photomicrograph of hepatic primordium in human embryo at 25 days’ gestation. The lower-power view shows the organs of the coelomic cavity. The higher-power inset shows cords of endodermal cells within the mesenchyme of the septum transversum, thus forming the hepatic primordium.
Once these vascular connections are made (Fig. 1.2 C), the circulatory pattern within the liver changes rapidly. The left umbilical vein becomes the principal source of blood entering the liver, partly because it comes to carry all the blood returning from the placenta when the right umbilical vein withers and disappears (generating the ‘double-artery/single-vein’ umbilical cord of the term fetus), and partly because the initial volume of blood returning from the gut in the vitelline veins is small. The definitive vascular pattern of the fetal liver is already established by the seventh week in embryos, about 17 mm long (Fig. 1.2 D).2 The originally paired vitelline veins have given way to a single portal vein that, on entering the liver, divides into right and left branches. Blood in the left umbilical vein
Forebrain Heart Liver
Hepatic trabeculae trabeculae
Figure
Mesenchymal lining of coelomic tract
Left hepatocardiac channel
Left umbilical vein
Sinus venosus
Right hepato-cardiac channel
Hepatic sinusoidal plexus
Middle hepatic vein
Hepatic sinusoidal plexus
Left umbilical vein
Origin of hepatic bud
Portal vein
Figure 1.2 A, Section through region of the hepatic bud in a human embryo of 25 somites (~26 days). B, Vascular channels associated with the developing liver, in a human embryo of 30 somites. C, Vascular channels in the human liver at a slightly later stage, showing the further extensive development of the hepatic sinusoidal plexus. D, Scheme of the portal hepatic circulation, in a human embryo of 17 mm (~7 weeks). (A and B redrawn from and C based on Streeter GL. Contributions to embryology of the Carnegie Institution of Washington, 1942;30:213–44; D redrawn from Lassau JP, Bastian D. Organogenesis of the venous structure of the human liver: a haemodynamic theory. Anat Clin 1983;5:97–102.)
traverses a venous extension in the falciform ligament and has a choice of three routes: (1) through the liver in branches that enter the sinusoidal plexus of the left half of the liver; (2) through the sinusoidal plexus of the right half of the liver, by retrograde flow through its connection with the left branch of the portal vein; and (3) through the ductus venosus traversing the short space between the porta hepatis to the inferior vena cava, to enter directly into the systemic venous circulation. By these routes, the converging bloodstreams from the definitive portal vein and indirectly from the umbilical vein enter the rapidly enlarging hepatic primordium through the porta hepatis. Intrahepatic mesenchyme condenses around the intrahepatic branching portal venous system, making up the ramifying portal tracts of the liver (see later discussion).
The hepatic artery is derived from the celiac axis. Arterial sprouts grow into the hepatic primordium from the porta hepatis along the mesenchyme of the portal tract system, spreading to the organ periphery as the fetal liver enlarges. These arterial sprouts appear to be the organizing element for formation of the intrahepatic biliary tree. The hepatic arterial system continues to proliferate and grow after birth, reaching an adult form only at 15 years of age.3–6 In the adult, about four arteries supply the largest intrahepatic bile ducts.7 At the level of the terminal portal tracts, there is a uniform 1 : 1 pairing of hepatic arteries and terminal bile ducts, and approximately two artery/bile duct pairs per single portal vein.8 The most terminal portions of the portal tree lose their portal veins, leaving only residual hepatic artery/ bile duct dyads, which themselves disappear into the parenchyma.8,9
Common cardinal vein
Left umbilical vein
Inferior vena cava
Ductus venosus (Dia. = 200 µm)
Left hepatic vein
Left umbilical vein (Dia. = 600 µm)
Right hepatic vein
Septum transversum
Liver
Right and left vitelline veins
Right umbilical vein
Sinus venosus Gut
Vitelline veins
(Dia. = 100 µm)
To complete this discussion, the rapid changes in hepatic circulation at birth must be considered. A sphincteric mechanism closes the ductus venosus at its proximal end, blood flow ceases in the umbilical vein, and the left side of the liver receives blood that now flows from right to left through the left branch of the portal vein. The closed segment of the umbilical vein between the umbilicus and the liver regresses to form the ligamentum teres; the ductus venosus undergoes fibrosis and becomes the ligamentum venosum
Hepatocyte ontogeny
Primitive hepatocytes are derived exclusively from the endodermal outgrowths of the hepatic diverticulum. Hepatocellular synthesis of alpha fetoprotein (AFP) begins at the earliest stage of liver differentiation, about 25–30 days after conception, and continues until birth. Glycogen granules are present in fetal hepatocytes at 8 weeks; the maximal glycogen reserve is achieved at birth, but the rapid onset of glycogenolysis over 2–3 days postpartum depletes the storage to approximately 10% of term levels. Hepatocellular haemosiderin deposits appear early in development, predominantly in periportal hepatocytes, and become more marked as hepatic haematopoiesis decreases (see later). Hepatocellular bile acid synthesis begins at about 5–9 weeks and bile secretion at about 12 weeks.10 Canalicular transport and hepatic excretory function, however, are still immature at birth and for 4–6 weeks postpartum, and therefore exchange of biliary solutes across the placenta (especially bilirubin) is important in the fetus. Within the sinusoids, endothelial cells, Kupffer cells and hepatic stellate cells appear at 10–12 weeks.11 When the adult liver is ultimately formed, hepatocytes constitute 80% of the cells in the normal liver. Of the remaining 20%, bile duct epithelial cells (cholangiocytes) comprise 1–3%, sinusoidal endothelial cells 10%, Kupffer cells 4%, and lymphocytes 5%.12
Bile duct system
The extrahepatic and intrahepatic biliary system is best understood if the liver is regarded as an exocrine gland. The endodermal cells of the hepatic primordium give rise not only to the epithelial parenchyma—the future hepatocytes—but also to the epithelial lining of the intrahepatic bile duct system. The extrahepatic bile ducts are derived from the caudal portion of the hepatic diverticulum, the
portion that does not invade the septum transversum but remains as a stalk connecting the foregut to the developing liver.13 The caudal part of this tethering diverticulum forms a secondary bud, constituting the epithelial primordium of the cystic duct and gallbladder. The epithelial lining of the extrahepatic bile ducts is continuous at its caudal end with the duodenal epithelium and at the cephalic end with the primitive hepatic sheets.
The intrahepatic ducts develop from the limiting plate of hepatoblasts that surround the mesenchyme of the primordial portal tracts. This has been known since the 1920s14 and was confirmed using immunohistochemical methods and monoclonal antibodies to (cyto) keratins and cell surface markers.15,16 Specifically, normal adult hepatocytes express keratins 8 and 18 (K8 and K18), whereas intrahepatic bile ducts, in addition, express K7 and K19. During the first 7–8 weeks of embryonic development, no intrahepatic bile ducts are evident, and the primordial epithelial cells express K8, K18 and K19. At about 9–10 weeks (27–30 mm embryos), primitive hepatocytes (hepatoblasts) surrounding large portal tracts near the liver hilum express these cytokeratins more intensely and form a layer of cells (Fig. 1.3) that ensheaths the mesenchyme of the primitive portal tracts to form the so-called ductal plate. This is followed by development of a second but discontinuous layer of epithelial cells which show a similar phenotypic change, and thus a network of segmentally double-layered bile duct precursor structures is formed.13,17 This process is recapitulated centrifugally along the length of the portal tract tree, from the hilum outward to the periphery.
Further remodelling of the plate then occurs. Invading connective tissue separates it from the liver parenchyma, and the tubular structures become incorporated into the mesenchyme surrounding the portal vein branches. The patterning of intrahepatic biliary tree development is harmonized with that of hepatic arterial development,18 suggesting that molecular signals emanating from the ductal plate help drive hepatic arterial growth. These signals include expression by cholangiocyte precursors of hepatocyte nuclear factor 6 (HNF6) or HNF1β growth factors, and vascular endothelial growth factor A (VEGF-A).19,20 This molecular coordination of bile duct formation and hepatic artery formation21 explains the pairing of hepatic arteries and terminal bile ducts observed in the adult human liver.8
The endodermal liver cells that are not contiguous to portal tracts lose K19 expression, instead maturing into hepatocytes within the parenchymal liver cell plates. Expression of the SRY-related HMG
Figure 1.3 Development of the ductal plate and of intrahepatic bile ducts. A, Increased expression of keratins in primitive hepatocytes at the interface with the mesenchyme of the primitive portal tracts; human fetus of 12 weeks’ gestation. B, Later stage showing a discontinuous double-layered plate of epithelial cells at the mesenchymal interface; note the formation of tubular structures (upper right) within this plate. Human fetus of 14 weeks’ gestation (immunoperoxidase staining); antibody (5D3) to low-molecular-weight keratins.
B A
box transcription factor 9 (SOX9) in a subset of ductal plate cells marks their differentiation into biliary precursor cells,22 with cholangiocyte precursors on the portal side of primitive ductal structures expressing SOX9, and those on the parenchymal side being negative for SOX9. These primitive ductal structures become surrounded by extracellular matrix and mesenchyme, 23 in the process acquiring mature cholangiocyte morphology and function around their full circumference. Ductal plate cells not expressing SOX9 transdifferentiate into periportal hepatocytes (forming the ‘limiting plate’, hepatocytes abutting portal tracts) and to hepatocytes lining the canals of Hering.24 The timing of biliary differentiation and morphogenesis is coordinated by SOX9, with SOX4 also playing a role.25 Key downstream molecular signals guiding cholangiocyte differentiation then include Notch, Wnt, transcription growth factor β, Hippo-Yap and fibroblast growth factor (FGF) signalling pathways.25,26
As the terminal bile ducts mature within the portal tract mesenchyme, epithelial tethers remain as a connection with the hepatic parenchyma.13 While traversing the portal tract mesenchyme, these structures are bile ductules, circumferentially lined by bile duct epithelial cells (cholangiocytes) derived from the ductal plate. As these channels impale the parenchymal interface, they become hemilunar, with half the circumference as bile duct epithelial cells and the other half as hepatocytes. These are the canals of Hering, which may penetrate the parenchyma for up to one-third the zonal distance to the terminal hepatic vein or may skirt the portal tract interface as a residual short canal.27 The canals of Hering are thought to harbor resident stem cells throughout life, serving as a source for a robust proliferative response after liver injury28,29 (Fig. 1.4).
Bile canaliculi between hepatocytes are first seen in human embryos at the sixth week, long before bile production begins at 12 weeks. They develop from membrane foldings between junctional complexes and appear as intercellular spaces within sheets of presumptive hepatocytes, thereby constituting an ‘apical’ luminal channel between hepatocytes. The bile canaliculi drain centripetally from the perivenous zonal region toward the periportal zone, discharging their fluid into the hemilunar canals of Hering, where the hepatocyte:bile duct epithelial cell connection occurs.13 At the level of hepatocytes, and in addition to the fluid pressure generated by active secretion of biliary solutes and fluid, 30 contraction of the hepatocellular subapical pericanalicular actin network provides a contractile mechanical force for propulsion of newly formed bile downstream.31
The entire process of intrahepatic bile duct development progresses centrifugally from the porta hepatis and also from the larger to the smaller portal tracts. However, this process may not be complete at 40 weeks’ gestation, and full expression of K7 is not found until
Portal vein Portal tract
Hepatic artery
about 1 month postpartum. Thus the intrahepatic bile duct system is still immature at birth.13 Indeed, the liver doubles in size in the first year of life and continues to grow incrementally until adulthood, arriving at a mass 10 times that at birth. Formation of the intrahepatic biliary tree is therefore not fully complete until many years after birth. Failure of remodelling and resorption during fetal liver development produces the ductal plate malformation,32,33 which is significant in the production of various congenital malformations of the intrahepatic biliary tree. Failure of remodelling has been observed in HNF6 and HNF1β knockout mice, indicating that these transcription factors in tandem play a role in normal remodelling of the ductal plate34 (see later). Furthermore, agenesis, injury to or destruction of the ductal plate in utero may be a factor in the development of intrahepatic biliary atresia32 (see Chapter 3).
Despite their common ancestry, mature hepatocytes and cholangiocytes of ductal epithelium in the adult liver are considered as distinct cell types. The epithelium of the terminal twigs of the biliary tree—the canals of Hering—includes typical hepatocytes and typical ductal cells, but no forms intermediate between the two.35 However, the adult liver retains multiple stem cell niches, including hepatic stem/progenitor cells in or near canals of Hering and biliary tree stem/progenitor cells within peribiliary glands along the larger intrahepatic bile ducts.36 When there is significant injury to either hepatocytes or cholangiocytes at the interface between portal tracts and parenchyma, a profound ductular reaction can occur.35 On repair of the injury, hepatocytes and cholangiocytes will return to expressing their normal respective keratins (K8, K18 for hepatocytes; K7, K19 for cholangiocytes).37
The limiting plate merits further comment.35,38,39 Referring back to embryological development, once the ductal plate has involuted, only canals of Hering remain at the portal tract–parenchymal interface as elements containing bile duct epithelial cells. The remainder of the interface is rimmed by mature hepatocytes, directly abutting the portal tract mesenchyme and representing the limiting plate. When liver injury occurs at the interface, involving destruction of hepatocytes and influx of inflammatory cells, the limiting plate is compromised or destroyed; this process is termed interface hepatitis. The canal of Hering–bile ductular compartment proliferates in response, giving rise to ductular reaction at the interface.
Haematopoiesis
Canal of Hering
Intralobular (variably present)
Intraportal
Bile ductule
Terminal bile duct
Figure 1.4 Schematic diagram of relationships among bile ducts, ductules and canals of Hering. (Data from Roskams TA et al. Nomenclature of the finer branches of the biliary tree: canals, ductules, and ductular reactions in human livers. Hepatology. 2004;39:1739–45.)
Hepatic haematopoiesis is a feature of the embryonic and fetal liver of mammals, including humans. The yolk sac is the initial site of haematopoiesis from primitive progenitor cells. Colonization of the liver by definitive erythroid-myeloid progenitor cells begins at about 6 weeks (10 mm embryo).40,41 Foci of haematopoietic cells appear extravascularly alongside the sheets of hepatocytes, and by the 12th week the liver is the main site of haematopoiesis, having superseded the yolk sac. Hepatic haematopoietic activity begins to subside in the fifth month of gestation, when the bone marrow becomes haematopoietic, and has normally ceased within a few weeks after birth. Parenchymal haematopoiesis is largely erythropoietic; haematopoiesis within portal tracts tends more toward granulocytes, megakaryocytes and monocytes.
Molecular control of liver development
As previously noted, the first morphological indication of development of the liver is an endodermal proliferation in the ventral part of the foregut, just caudad to the cardiac mesoderm and septum transversum, at the 18th postfertilization day in the human embryo. Ventral foregut endoderm is marked by expression of the homeobox transcription factor gene, HHEX42, and over the ensuing days is subdivided into
Parenchyme
hepatic (HNF1β)-expressing or pancreatic homeobox factor 1 (PDX1)expressing progenitor domains, a process called specification. 43 Beginning about the 23rd day of gestation, the cardiogenic mesoderm provides an FGF signal that is important for proliferation of the precursor endodermal cells44; both FGF1 and FGF2 appear to be involved.45 These precursor cells proliferate and invade as hepatoblasts into the surrounding septum transversum, forming the liver bud proper. Liver bud outgrowth occurs through about the 56th day of gestation, without further differentiation of the hepatoblasts. Beginning about days 56–58 in the fetal liver, terminal differentiation of hepatoblasts begins, continuing for the remainder of pregnancy as the mature structure of the liver is laid down.
Many of the molecules and receptors involved in regulation of the hepatoblasts and subsequent hepatocyte and cholangiolar differentiation have now been identified.46–49 It has become increasingly apparent that cellular interactions with nonparenchymal cells play a key role in early hepatic development.47,50,51 The sheets of hepatoblasts that invade the septum transversum in the developing mouse liver express the transcription factors HNF1 β and HNF4α, while the surrounding mesenchyme expresses GATA447; the migratory properties of the hepatoblasts appear to require a homeobox gene PROX1 GATA6 also appears to be essential in the formation of the early liver bud, as do FoxA1 and FoxA2 (under the induction of HNF1β).52–54 Some of these factors (e.g. GATA4) appear to be important in early stimulation of hepatocyte-specific gene expression, including AFP, transthyretin and albumin; this occurs before morphological change toward a hepatocyte or a cholangiocyte phenotype.47
Expression of bone morphogenic protein (BMP) by the septum transversum activates the expression of GATA4.47,55 Wnt signalling is now also known to play a role in liver induction; liver development requires its repression by secretion of Wnt inhibitors by the endoderm.56 Studies utilizing embryonic stem cells and RNA technology have reinforced the role of FoxA2 in hepatocytic differentiation.57 The myriad of transcription factors and signalling molecules identified thus far that may be involved in early liver induction are summarized elsewhere.46–48 Vasculogenic cells (angioblasts) are also critical for these earliest stages of organogenesis, before blood vessel formation. In the mouse embryo, angioblasts were found as a loose necklace of cells interceding between the thickening, hepatically specified endoderm and the mesenchyme of the septum transversum. This mesenchymal-epithelial interaction precedes the emergence of the liver bud and persists throughout further liver development.
During later fetal liver development there is continued expansion of the parenchymal cell mass. This involves both stimulatory signals and protection from tumour necrosis factor alpha (TNFα)-mediated apoptosis; these phenomena involve the AP-1 transcription factor c-Jun, hepatoma-derived growth factor (HDGF), the Wnt signalling pathway, the nuclear factor-κB pathway and the hepatocyte growth factor (HGF)–c-met pathway, among others.47,58 In the final step of differentiation, PROX1 and HNF4α direct hepatoblasts to a hepatocyte phenotype, whereas HNF6, SOX9 and HNF1β guide the hepatoblast to a cholangiocyte phenotype.48 Notch signalling is important for creating the proper balance in the numbers of hepatocytes and cholangiocytes.59,60 Development and maintenance of hepatocytic differentiation and function are under the control of HNF4 α 61 Maturation of primitive bile ductular structures into mature bile ducts is promoted by LKB1, a tumor suppressor encoded by the STK11 gene,62 and by the transcription factors SOX4 and SOX9.63
Macroanatomy of the liver
The liver lies almost completely under the protection of the rib cage, projecting below it and coming into contact with the anterior abdominal wall only below the right costal margin and the
xiphisternum. The liver is moulded to the undersurface of the diaphragm, the muscular part of which separates it on each side from the corresponding lung and pleural sac. The liver is separated by the central tendon of the diaphragm from the pericardium and the heart. The anterior dome of the liver and its medial, ventral and lateral aspects are covered by the Glisson capsule, the connective tissue sheath of the liver with its glistening peritoneal surface. The posterior surface of the liver is the least accessible, and its relationships are of some clinical importance. It includes the following, from right to left:
1. The ‘bare area’, which is surrounded by the reflections of peritoneum that form the superior and inferior layers of the coronary ligaments. It lies in direct contact with the diaphragm, except where the inferior vena cava (IVC), the right adrenal gland and the upper part of the right kidney intervene.
2. The caudate lobe, which lies between the IVC on the right and, on the left, the fissure of the ligamentum venosum and the attachment of the lesser omentum. The caudate lobe projects into the right side of the superior recess of the lesser sac and is covered by peritoneum; behind it lies the right crus of the diaphragm, between the IVC and the aorta.
3. A small area on the left posterior surface, covered by peritoneum and apposed to the abdominal oesophagus.
The traditional division of hepatic anatomy into right and left lobes (delineated by the midline falciform ligament) and caudate and quadrate lobes is of purely topographical significance. A more useful and important subdivision is made on the basis of the branching pattern of the hepatic artery, portal vein and bile ducts. As these are followed into the liver from the porta hepatis, each branches in corresponding fashion, accompanied by a branching tree of connective tissue, derived from the original mesenchyme of the developing liver. On this basis of vascular anatomy, the liver is divided into right and left ‘physiological’ lobes of about equal size. The plane of separation between these two ‘hemilivers’ corresponds, on the visceral surface of the liver, to a line extending from the left side of the sulcus for the IVC superiorly, to the middle of the fossa for the gallbladder inferiorly. This parasagittal plane lies approximately 2–3 cm right of the midline. Each lobe has been further subdivided into portobiliary-arterial segments.
Within each hemiliver, the primary branches of the portal vein divide to supply two main portal segments, each of which is further divided horizontally into superior and inferior segments. According to this scheme, there are thus eight segments, or nine if the dorsal bulge of the liver between the groove of the IVC and midline—the caudate lobe—is separately designated. Using the Couinaud system for designating segments64 (Fig. 1.5), the numerical assignments are caudate lobe (I); left lobe: medio-superior (II), medio-inferior (III), latero-superior (IVa) and latero-inferior (IVb); and right lobe: medioinferior (V), latero-inferior (VI), latero-superior (VII) and mediosuperior (VIII). Because segment IVb lies between the falciform ligament medially and the gallbladder fossa and groove for the inferior vena cava laterally, this region also is designated the quadrate lobe. Numerology aside, the caudate lobe stands at the watershed between right and left vascular and ductal territories; its right portion in particular may be served by right or left vessels and ducts, although its left part is almost invariably supplied by the transverse portion of the left branch of the portal vein.
These nine hepatic segments are separate in the sense that each has its own vascular pedicle (arterial, portal venous and lymphatic) and biliary drainage. Although there is substantial opportunity for vascular anastomoses between the different hepatic segments, there are no major intrahepatic vascular connections between the right and left hepatic arteries or portal vein systems. The virtually
Left and middle hepatic veins
Right hepatic vein
Hepatic
Figure 1.5 Segmentation of the liver based on principal divisions of the portal vein and hepatic artery (see text for numbers). (Modified from Moore KL, Dalley AF. Clinically oriented anatomy, 4th ed. Philadelphia: Lippincott Williams & Wilkins; 1999, p. 268, copyright 1999 from Lippincott Williams & Wilkins [http://lww.com].)
independent vascular supply for each segment has been shown by studies in living humans, using computed tomography (CT), magnetic resonance imaging (MRI) and ultrasonography (US), together with intravenous (IV) contrast injections, which allow ready recognition of the liver’s major vascular structures. 65 This vascular anatomy underpins the surgeon’s ability to perform a partial hepatectomy and achieve haemostasis for the residual liver, despite the absence of defining connective tissue septa between segments.66
While the branches of the hepatic artery and portal vein and the tributaries of the hepatic ducts run together and serve segments of liver, the hepatic veins run independently and are intersegmental. As with the portal vein, they lack valves. The three major hepatic veins—the right, intermediate and left (the intermediate and left often forming a common trunk)—enter the upper end of the retrohepatic segment of the IVC. The terminal portion of each hepatic vein frequently is at least partially exposed above the posterior surface of the liver, where the veins are vulnerable to being severed by blunt abdominal trauma. In addition to these major hepatic veins, several accessory hepatic veins (about five per liver) open into the lower part of the hepatic segment of the IVC.67 Because the caudate lobe regularly drains directly into the IVC, it may escape injury from venous outflow block.
Microanatomy of the liver
Definition of the fundamental structural and functional ‘unit’ of the liver has been an elusive goal since the first description of liver lobules by Weppler in 1665 (cited by Bloch68). Over the years, several concepts of the basic structural organization of the liver have been operative. The hexagonal ‘lobule’ described by Kiernan 69 in 1833 remains the standard by which hepatic microarchitecture is named (Fig. 1.6). ‘Portal tracts,’ containing a portal vein, hepatic artery and bile duct, constitute the periphery of the hexagonal lobule, occupying three of the six apices of the hexagon. The effluent hepatic vein is at the centre of the lobule, thus its name ‘central vein’.70 To
‘Nodal’ point of Mall
Figure 1.6 Diagrammatic representation of the simple acinus and the zonal arrangement of hepatocytes. Two neighbouring ‘classic lobules’ are outlined by dashed lines, and the acinus occupies adjacent sectors of these. Although only one channel is shown as forming the central core of the acinus, the acinus is arranged round the terminal branches of the portal vein, hepatic artery and bile ductule. Zones 1, 2 and 3 represent areas which receive blood progressively poorer in nutrients and oxygen; zone 3 thus represents the microcirculatory periphery; and the most peripheral portions of zone 3 from adjacent acini form the perivenular area. The nodal points of Mall represent vascular watershed areas where the terminal afferent vessels from neighbouring acini meet. PT, Portal tract; ThV, terminal hepatic vein (central vein of ‘classic lobule’); 1, 2, 3, microcirculatory zones; 1′, 2′, 3′ , microcirculatory zones of neighbouring acinus. (Data from Rappaport AM et al. Subdivision of hexagonal liver lobules into a structural and functional unit: role in hepatic physiology and pathology. Anat Rec 1954;119:11–34.)
this day, regions of the parenchyma are referred to as ‘periportal’ or ‘pericentral’.
More useful are subdivisions of the classic hexagonal lobule into smaller functional physiological units. The most robust concept is the ‘liver acinus’ (see Fig. 1.6), defined by Rappaport et al.71 in 1954. In this formulation the portal tract is at one point of the base of a triangle, and the effluent vein is at the sharp apex of the triangle. The vein is regarded as the ‘terminal hepatic venule’. In the idealized hexagonal lobule, there are six acinar units. However, actual liver microanatomy is not ideal, and there are ever-variable relationships between portal tracts and terminal hepatic venules across the two- and three-dimensional anatomy of the liver parenchyma. Regardless, a key element of the Rappaport ‘acinus’ is portal venules derived from portal veins of various sizes, which penetrate the parenchyma and traverse the base of the triangle. Blood emanating from these venules perfuses the parenchyma across a broad zonal front, converging at the apex of the terminal hepatic vein. The most proximal zone, defined by the blood flow, is zone 1, with a midzonal zone 2 and a terminal zone 3 recapitulating the ‘pericentral zone’ of the hexagonal lobule. Importantly, zone 1 is not ‘pericentral’; it is an ellipsoid region of higher-oxygenated parenchyma, with its long axis being the base of the isoceles triangle (remembering that acini emanate symmetrically on both sides from the penetrating venule). Likewise, the septal venule is orthogonal to a line drawn between parallel terminal hepatic veins coursing through the parenchyma. In three dimensions the perfect geometry is an interlocking system of triangular acini that can be viewed as contributing to the larger hexagonal lobules.
Inferior vena cava
Other formulations for liver microanatomy have been proposed.72–75
In the ‘primary hepatic lobule’ model, Matsumoto et al.72 regarded the ‘vascular septum’ emanating from the portal tract (the ‘penetrating venule’ of the liver acinus) as being at the origin of the unit’s blood flow. Later, the ‘cholehepaton’76 was viewed as similar to the nephron and synthesized concepts of a ‘choleon’70 and ‘hepatic microcirculatory unit’.77 A group of hepatocytes, again a triangle with the terminal hepatic vein at its apex, is drained by a single bile ductule–canal of Hering (discussed later) at the base of the triangle.75 In this way a countercurrent cholehepaton unit is described, with blood moving through sinusoids from the base to the apex of the triangle and bile moving from apex to base in return.
Most of these concepts represent different ways of looking at an organ of deceptive structural complexity and with a multitude of functions. However, a basic difference between the liver acinus and the other ‘lobule-based’ concepts makes them mutually exclusive. Early editions of this text stated that the concept of the ‘liver acinus’ was proving to be of the greatest value to the pathologist in the interpretation of disordered structure and function. It represented the structural and functional liver unit concept that allowed for an explanation of important histopathological features, such as portalcentral bridging, hepatic necrosis and fibrosis. However, the concept of the liver acinus was based on vascular injection of coloured gelatin-based infusion fluids. In 1979 and 1982, Matsumoto et al.72,78 used meticulous vascular reconstruction of the liver to conceptualize the primary hepatic lobule. Among devoted hepatic anatomists, this last concept has gradually gained attention, and several other concepts (e.g. choleon, hepatic microcirculatory unit, choleohepaton, single sinusoid–hepatic functional unit) can be considered as variants of or existing within the primary lobule.
Given all these considerations, the terminology of hepatic microanatomy is somewhat fluid and certainly mixed. The practice of liver histopathology exists mostly in the two worlds of the classic ‘lobule’ and Rappaport ‘acinus’. We thus ask the reader to understand the use of these mixed terminologies in subsequent chapters.
Anatomy of hepatic microcirculation
Portal circulation
The portal tract derives its name from the ramifications of the portal venous system through the liver. The portal system also provides the tracts along which the hepatic artery system and biliary tree travel, giving rise to the alternate term ‘portal triad’. However, as the terminal portal tracts reach their own terminus, the portal vein system ends, ironically leaving a final portal tract ‘dyad’ lacking a terminal portal vein but containing hepatic artery–bile duct pairs before these also end after a short distance. In the periphery of the normal adult liver sampled by percutaneous liver biopsy, portal ‘triads’ containing portal vein, hepatic artery and bile duct profiles constitute only 70% of portal tracts. Careful histological examination also reveals an additional 30% of diminutive ‘portal dyads’ containing only hepatic artery and bile duct profiles.8 Lastly, the portal system ramifies through approximately 17–20 orders of branches to supply the entire corpus of the liver.79 The subdivisions are not strictly dichotomous, however, in that one branch may ultimately have fewer subbranches than another. Thus the liver ultimately has an irregular lobular organization at the microscopic level.
Beginning at the porta hepatis, the portal vein divides into successive generations of distributing or conducting veins, so called because they do not directly feed the sinusoidal circulation. The vein diameters remain in the macroscopic range, introducing negligible vascular resistance. According to their diminishing position in the hierarchy of branching, they may be classified as interlobar, segmental and interlobular. The portal venous system branches in a nondichotomous
manner, such that smaller portal tracts may branch off conducting portal tracts without the latter losing their conducting capability. These further branches of the portal system are those that produce the smallest portal veins, which do distribute their blood into the sinusoids. These succeeding branches are (1) the preterminal portal venules, microscopically found in portal tracts of triangular cross section, and (2) the terminal portal venules, which taper to about 20–30 µm in diameter and are surrounded by scanty connective tissue in portal tracts of circular rather than triangular cross section. From both the preterminal and terminal portal venules arise very short side branches, designated inlet venules, which have an endothelial lining with a basement membrane and scanty adventitial fibrous connective tissue but no smooth muscle in their walls. They pass through the periportal connective tissue sheath and enter into the parenchyma to open into the sinusoids. These inlets are reported to be guarded by sphincters composed of sinusoidal lining cells—the afferent or inlet sphincters.80 Some early branching of the smallest conducting veins may produce more than one portal vein within some portal tracts, and these supply only those sinusoids which abut the canal.
Drawing on the anatomical studies of Matsumoto et al.,72,78 the conducting portal system and the terminal portal branches both give rise directly to penetrating inlet venules. The inflow-front for portal venous blood thus has a sickle shape. This is at variance with the concept of the acinus, in which portal blood flow exhibits radial symmetry only around the inlet venule arising from terminal portal vein branches. Moreover, the inlet venules do not run the entire length of the distance between two portal tracts, but rather taper off into a sinusoidal configuration near the middle of the interportal distance. In other words, the vascular watershed areas are not located at the nodal points of Mall (see Fig. 1.6), but at the midpoint of the interportal distance (midseptum M of Zou et al.81). Zonal gradients of metabolic activities and of enzyme histochemical staining patterns also conform with the sickle-zone pattern, not with the acinus diagram.71 The sickle-zone pattern has been confirmed by others.82–84 It is also important to note that the septal venules are not orthogonal to the portal tract, but in three dimensions follow a somewhat arcuate course into the parenchyma.
The importance of keeping this more sophisticated anatomical perspective becomes clear when examining the damaged liver. For example, according to the acinar concept, with severe hepatic congestion involving destruction of hepatocytes in acinar zone 3 and potentially in zone 2, the surviving parenchyma of acinar zone 1 would appear clover shaped, with the portal tract at its centre, but still damaged. However, Matsumoto et al.72 claim that immediate periportal damage actually never occurs in vascular insufficiency or chronic venous congestion, and that typically the liver biopsy always shows sickle zones standing in relief.
Arterial circulation
The hepatic artery supplies branches throughout the portal tract system. In the largest interlobar portal tracts, there are typically four hepatic arteries accompanying the interlobar bile ducts.7 The hepatic artery/bile duct ratio drops until, in the most distal portal tracts, hepatic arteries are paired in close proximity with interlobular bile ducts in a 1 : 1 ratio. Even at this level, there are typically two hepatic artery–bile duct pairs per portal vein in a peripheral portal ‘triad’.8
The terminal blood flow of the arteries is by three routes: into a plexus around the portal vein, into a plexus around a bile duct, and into terminal hepatic arterioles.79 The perivenous plexus is characteristically distributed around interlobar, segmental and interlobular portal vein branches within the portal area; it drains into hepatic sinusoids. Occasional arterioportal anastomoses between perivenous arterioles
and terminal portal venules have been observed, but the frequency of these in normal human livers is uncertain.79,80 By the level of the terminal portal veins, the arteriolar plexus is absent.
A peribiliary arterial-derived plexus supplies all the intrahepatic bile ducts. Around the larger ducts the peribiliary plexus is two layered, with a rich inner, subepithelial layer of fine capillaries and an outer, periductular venous network which receives blood from the inner layer. The smallest, terminal bile ducts have only a single layer of fine capillaries. Ultrastructural studies have shown that the capillaries are lined by fenestrated endothelium.85 The peribiliary plexus drains principally into hepatic sinusoids. The peribiliary plexus develops in parallel with the development of the intrahepatic bile ducts, spreading from the hepatic hilum to the peripheral area of the liver and becoming fully developed with the full maturation of the biliary system.86 In addition to providing the vascular supply to bile ducts, the peribiliary vascular plexus is thought to be involved in reabsorption of bile constituents (including bile acids) taken up apically by bile duct epithelial cells and secreted across their basal plasma membrane into the portal tract interstitium, constituting a ‘cholehepatic’ circulation.87 The cholehepatic reuptake of biliary substances may play a key adaptive role during times of downstream bile duct obstruction, because these solutes may be ‘dumped’ into the systemic circulation for disposal by the kidneys.88
Terminal hepatic arterioles have an internal elastic lamina and a layer of smooth muscle cells, and they open into periportal sinusoids via arteriosinus twigs. Although some mammalian species exhibit hepatic arterioles that penetrate deeply into the parenchyma before entering sinusoids near to the hepatic veins, reports of such penetrating arterioles in humans have been disputed.89 Regardless, isolated parenchymal arterioles may sometimes be seen in liver biopsies. Ekataksin77 has suggested that these vessels supply isolated vascular beds in the parenchyma.
Venous drainage
Having perfused the parenchyma through the sinusoids, blood enters the terminal hepatic venules (‘central veins’ of classic lobules). Scanning electron microscopy (SEM) has clearly demonstrated in the walls of terminal hepatic veins the fenestrations through which the sinusoids open,90 and the astute observer can see these sinusoidal openings into terminal hepatic veins in histological sections. The terminal vein branches unite to form intercalated veins, which in turn form larger hepatic vein branches, whose macroanatomy is described earlier. The venous anatomy does not strictly parallel the distribution of the portal system, because hepatic veins traverse between portal system-defined lobules as the venous system exits the liver. This is understandable; ultimately the hepatic veins need to exit through the dorsum of the liver, whereas the portal system enters the liver ventrally. The hepatic venous system also does not ramify as extensively as the portal system, so there is a slight preponderance of terminal portal tracts to terminal hepatic veins throughout the liver.
Regulation of hepatic microcirculation
Total hepatic blood flow in normal adults under resting conditions is between 1500 and 1900 mL/min, or approximately 25% of cardiac output.91 Of this, about two-thirds is supplied by the portal vein and the remainder by the hepatic artery. Because of variations in splanchnic blood flow, portal vein blood flow increases after feeding and decreases during exercise and sleep,92 the so-called hepatic arterial buffer response (HABR).93 Direct external regulation of hepatic blood flow is mediated primarily through the hepatic artery, influenced by such vascular mediators as angiotensin II.94 During times of reduced
portal venous blood flow, as during acute occlusion or in cirrhosis, the HABR also helps maintain hepatic perfusion so as to support its core metabolic functions, although it cannot fully compensate for lost portal perfusion.95
Intrinsic regulation of blood flow within the liver is quite complex. This account is based on the work of McCuskey96 but derives ultimately from the pioneering studies of Knisely et al.,97 using quartz rod transillumination of living liver. Anatomical arterioportal relationships are summarized in Fig. 1.7, which shows a terminal (penetrating) portal venule from which a series of sinusoids originates, as well as a hypothetical accompanying terminal hepatic arteriole (internal diameter ~10 µm). As noted, whether this arteriole actually penetrates the parenchyma is disputed. Regardless, various connections exist between arteriole and sinusoid, with all found in the periportal areas and all of internal diameter no greater than the diameter of an erythrocyte.
In accordance with macroscopic blood flow, approximately twothirds of the intrahepatic blood supply ultimately comes from the portal venules, whose inlets are controlled by sphincters—afferent or inlet sphincters—composed of sinusoidal endothelial cells. For the remaining third of blood supply, arterial blood flow to the sinusoids is intermittent and determined by independently contractile smooth muscle sphincters in the walls of hepatic arterioles and their arteriolosinusoidal branches. Blood flowing into a group of sinusoids could therefore be arterial, venous or mixed, depending on sphincteric activity of entering venular and arteriolar channels and the distance of the originating sinusoid from the portal tract along the penetrating venule.
There also is heterogeneity in the blood flow through the sinusoids. In the upstream zone the sinusoids form an interconnecting polygonal network. Downstream, however, the sinusoids become organized as convergent parallel channels which drain into the terminal hepatic venule, a convergent architecture that is evident histologically at medium power. In this downstream region, short intersinusoidal channels connect adjacent parallel sinusoids. Blood entering the hepatic venules passes through efferent or outlet sphincters which, like the inlet sphincters, are composed of sinusoidal endothelial cells.
Figure 1.7 Schematic showing relationships of hepatic arteriole (HA), portal venule (PV), sinusoids (S) and hepatic venule (HV). Arteriolosinusoidal branches (AS) may open in various ways into the sinusoids, and blood flowing to a group of sinusoids could therefore be arterial, venous or mixed. Blood flow through the sinusoids is determined by the activity of ‘sphincters’ (SP) in the arteriolar wall and of sphincteric mechanisms at the inlet and outlet of the sinusoids. (Based on McCuskey RS. Hepatic microcirculation. In: Bioulac-Sage P, Balabaud C, editors. Sinusoids in human liver: health and disease. Rijswijk: Kupffer Cell Foundation, 1988.)
The precise mechanisms that regulate the hepatic microcirculation remain controversial. 96,98 The potential morphological sites for regulating blood flow through sinuosids, with secretion of chemokines that influence hepatic stellate cells. The portal and hepatic venules and the hepatic arterioles contain some smooth muscle cells in their wall and are therefore contractile. However, the principal site of regulation is thought to reside in the sinusoids themselves. The sinusoidal endothelial cells respond to a variety of vasoactive substances, and by contracting or swelling, they may vary the diameter of the sinusoid lumen. Thus, blood flow through individual sinusoids is variable. Where the lumen is narrowed, blood flow may be impeded by leukocytes that transiently plug the vessel, a feature that is more common in the narrower, more tortuous periportal sinusoids. 99 It seems likely that flow through some sinusoids may be intermittent, whereas others have relatively constant rates of blood flow. Arterial blood flowing into an individual sinusoid through a dilated arteriosinusoid may increase the rate of blood flow.
Kupffer cells could affect the rate of blood flow through sinusoids, with particular attention to a role for hepatic stellate cells. HSCs are responsive to vasoconstrictors such as endothelin-1.100 Given their contractile function (see later), HSCs have been implicated in regulation of sinusoidal blood flow.101 In addition, reduction of the portal blood flow has been shown by in vivo microscopy to reduce sinusoidal blood flow, with a considerable decrease in sinusoidal diameter, changes that were reversed on restoring the portal blood flow.102 It has been suggested that the stellate cells, whose long, slender processes surround the sinusoids, may be responsible for producing these changes.
Functional heterogeneity in the liver
Hepatocyte heterogeneity was recognized as early as the 1850s,103 when the heterogeneous contribution of different hepatocytes to bile secretion was described. Many aspects of liver physiology and metabolism exhibit a heterogeneous distribution along the portocentric axis. Hepatocytes in the periportal zone have a higher capacity for gluconeogenesis and fatty acid metabolism, whereas perivenous hepatocytes have a higher capacity for detoxification.104 This heterogeneity is reflected in hepatocyte ultrastructure, including increased smooth endoplasmic reticulum with its biotransforming enzymes in the perivenular region, the hepatocyte complement of mitochondria with their attendant oxidative capacity and gene expression.105 The concept of metabolic zonation is therefore operative. 106,107 As first proposed for carbohydrate metabolism, opposite metabolic pathways such as gluconeogenesis and glycolysis can be carried out simultaneously by hepatocytes in the periportal and the centrilobular region, respectively. Although this possibility for ‘futile cycles’ may seem at first to be inefficient, the presence of dynamically opposed, interlocking metabolic pathways within individual hepatocytes and between hepatocytes in different positions in the lobule allows for exquisitely rapid regulation of metabolic function, including rapid reversal of the metabolic output of the organ.108 The presence of metabolic zonation for essentially all liver functions reflects a potentially important level of overall metabolic control. Dysregulation of hepatic zonation may contribute in part to the pathophysiology of metabolic liver diseases such as the metabolic syndrome.109
Two types of zonal heterogeneity in the liver are (1) the gradient versus compartment type of zonation and (2) the dynamic versus stable type of zonation.110 In the gradient type, all hepatocytes are able to express a particular gene, but the level of expression depends on the position of the hepatocyte along the portocentral radius. Examples include key regulatory enzymes of carbohydrate metabolism, cytosolic phosphoenol-pyruvate carboxykinase I (PCK) and
glucokinase. In the compartment type of zonation the expression of genes is thought to be restricted to either the periportal or the perivenular compartment. A striking example of compartmental zonation is a key enzyme of ammonia metabolism, glutamine synthase (GS), which in normal liver exhibits strict localization to hepatocytes rimming the terminal hepatic vein. The dynamic type of zonation is characterized by adaptive changes in expression in response to changes in the metabolic or hormonal state, regardless of where the enzyme is zonally located (e.g. PCK, tyrosine transaminase, CPS, ornithine aminotransferase). The stable type of zonation, on the other hand, is characterized by the virtual absence of dynamic adaptive change (e.g. fructose-1,6-biphosphatase, GS).
The molecular mechanisms regulating metabolic zonation are varied. In the case of bile formation, physiological availability of biliary solutes in periportal blood is a major determinant, independent of hepatocellular expression of relevant transporters.110 Fatty acid β-oxidation also is periportal under normal conditions, but the zonation can be affected by nutritional state and oxygen supply from blood.111 Likewise, gradients of oxygen and hormones across the lobule are thought to play key roles influencing expression of metabolic enzymes.104
The Wnt/β-catenin signalling pathway plays a key role in regulating liver zonation.112–116 Specifically, the precise zonal localization of several β -catenin-regulated liver-specific genes, including GS, transporter 1 of glutamate (GLT1) and ornithine aminotransferase (OAT), are under APC control. Targeted disruption of APC inhibition, or constitutive activation of the Wnt/β-catenin signalling pathway, leads to panlobular expression of these genes involved in ammonia metabolism. The resultant severe metabolic perturbation is lethal in experimental conditions. Conversely, experimental deletion of β-catenin results in loss of GS expression irrespective of whether APC is present.114 The zonation of bile acid metabolism and transport is the most heavily targeted by β-catenin, partly through the xenobiotic nuclear receptors involved in bile acid metabolism.116 Lastly, hormones and the sympathetic and parasympathetic nervous systems also influence zonation of hepatic metabolism, including their influence on the hepatic microcirculation.117,118 However, differences in hepatic innervation between humans and experimental animals hinder an understanding of the importance of innervation in humans.
Zonal heterogeneity is a feature that characterizes not only hepatocytes, but other components of liver tissue as well. Sinusoids have a more tortuous course, more frequent intersinusoidal anastomoses and a narrower lumen in the periportal area, whereas they appear straighter with less intersinusoidal sinusoids and a broader lumen in centrilobular areas.119 The sinusoidal endothelial cells have higher porosity (by fenestrae) in the centrilobular region, display different wheat-germ agglutinin-binding patterns in periportal versus centrilobular endothelial cells and show portocentral gradients in mannose receptor-mediated endocytosis and in production of reactive oxygen metabolites.120 In a three-dimensional reconstruction study of parenchymal units in rat liver, Teutsch et al.121 emphasized the importance of considering three-dimensionality for an adequate functional interpretation of the metabolic heterogeneity of hepatocytes. If the three-dimensionality of the parenchymal units is not taken into consideration, calculations show that changes at the origin of sinusoids are likely underestimated, whereas changes at the termination of sinusoids are overestimated. This should also apply in the interpretation of sections from pathologically altered liver tissue.121
The hepatic stellate cells display marked heterogeneity in structure and function based on their zonal (portal-central) and regional (portal versus septal sinusoidal) distribution in the hepatic lobules. 122 They have more cytoplasmic processes with thorn-like microprojections
in the centrilobular zone, whereas their desmin immunoreactivity and vitamin A storage are greater in the periportal zone.
Kupffer cells are located preferentially in periportal regions, and some functional and morphological heterogeneity has been ascribed to their location. Thus, Kupffer cells in periportal zones are larger, contain more heterogeneous lysosomes and are more active in phagocytosis than their centrilobular counterparts.123 In contrast, in areas around centrilobular veins, Kupffer cells are smaller and more active in terms of cytokine production and cytotoxicity.124
The extracellular matrix components in the space of Disse may vary along the portal-central axis. Collagens IV and V and laminin predominate in the area of transition between the bile ductule–canal of Hering units and hepatocytes at the periportal lobular periphery. Fibronectin and collagens III, IV and VI are the predominant components along the portovenous parenchymal axis.125
Ultrastructural anatomy of hepatocyte
Hepatocytes are polyhedral cells approximately 20 to 30 µ m in diameter, with a volume of approximately 5000 µm3. Their organization into anastomosing plates of the parenchyma is best illustrated by SEM (Fig. 1.8). The liver cell plates anastomose extensively in the periportal region but become more simplified and radially oriented as they approach the terminal hepatic vein.
Plasma membrane
As with other epithelial cells, the hepatocyte is highly polarized (Fig. 1.9). Within its plasma membrane, three specialized regions, or domains, are recognized: sinusoidal, which faces the sinusoid and the perisinusoidal space; lateral, facing the intercellular space between
hepatocytes; and canalicular, bounding that specific part of the intercellular space constituting the bile canaliculus. 126,127 Using a more generic terminology, the sinusoidal and lateral domains constitute the basolateral plasma membrane of the hepatocyte, and the canalicular domain is the apical domain. This polarity is largely maintained by the tight junctions formed between adjacent hepatocytes, which delineate the basolateral domain from the canalicular domain and create a barrier between fluid in the intercellular space and bile in the canaliculus.128,129 In addition to tight junctions, there are also gap junctions and desmosomes in the lateral domain, and it is across lateral-domain gap junctions that intercellular communication takes place. Stereological studies in the rat have shown that the basolateral, canalicular and lateral domains constitute approximately 70%, 15% and 15%, respectively, of the total cell surface area.130
The domains of the hepatocyte plasma membrane are not simply topographical entities. They are specialized to serve different basolateral and apical functions of the hepatocyte. Molecular differences include composition of the lipids in the plasma membrane, the complement of membrane proteins, function of endocytic and exocytic compartments and relationship to the cytoskeleton.110,122,123,131 Beyond direct regulation of membrane protein function, hepatocytes can dynamically regulate actual membrane lipid content and the concentration of specific proteins in each domain, providing a powerful additional mechanism for functional control of plasma membrane function.132,133
Sinusoidal domain
The sinusoidal surface of the hepatocyte faces the perisinusoidal space of Disse, the tissue space between hepatocytes and the endothelial sinusoidal lining cells. The hepatocyte sinusoidal surface is covered with abundant microvilli, each measuring 0.5 µ m long but not
Figure 1.8 Plates of hepatocytes viewed by scanning electron microscopy. A, The fracture plane highlights the lateral faces of hepatocytes (H), with bile canaliculi (arrow) in view. The labyrinth of sinusoidal spaces (S) is evident between hepatocyte plates. B, Different image shows the sinusoidal spaces to better advantage. A Kupffer cell (KC) is present within the luminal space of the sinusoid. (Modified from McCuskey RS. Functional morphology of the liver with emphasis on its microvasculature. In: Tavoloni N, Berk PD, editors. Hepatic transport and bile secretion. New York: Raven Press, 1993. copyright 1993 from Lippincott Williams & Wilkins [http://lww.com].)